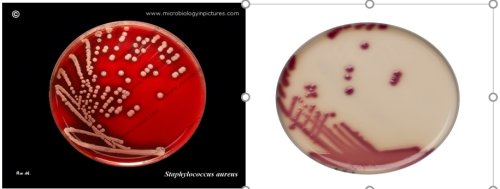
Picture4.png

Xét nghiệm nuôi cấy – kháng sinh đồ xác định độ nhạy cảm của vi khuẩn/ vi nấm với thuốc
I.
Xét nghiệm nuôi cấy - kháng sinh đồ là một xét nghiệm Vi sinh học quan trọng, được coi là "tiêu chuẩn vàng" để chẩn đoán và hướng dẫn điều trị hiệu quả các bệnh lý nhiễm trùng do vi khuẩn/ vi nấm.
Tình trạng kháng kháng sinh (KKS) là một trong những mối đe dọa sức khỏe toàn cầu nghiêm trọng nhất hiện nay. Tình trạng vi khuẩn kháng lại nhiều nhóm kháng sinh (đa kháng) và thậm chí kháng lại tất cả các loại kháng sinh (toàn kháng) đang gia tăng ở mọi khu vực, khiến các lựa chọn điều trị cuối cùng cũng dần trở nên vô hiệu. Tổ chức Y tế Thế giới (WHO) và các báo cáo toàn cầu đã xếp KKS vào danh sách các mối đe dọa sức khỏe nghiêm trọng nhất. Chỉ riêng năm 2019, trên thế giới có khoảng 4,95 triệu ca tử vong có liên quan đến KKS và 1,27 triệu ca tử vong trực tiếp do nhiễm khuẩn kháng thuốc. KKS được dự báo sẽ gây thiệt hại kinh tế toàn cầu lên tới 100 nghìn tỷ USD vào năm 2050 và có thể gây ra khoảng 10 triệu ca tử vong mỗi năm.
Việt Nam là một nước khu vực nhiệt đới, có điều kiện khí hậu rất phù hợp cho các vi sinh vật phát triển, do đó, tình trạng nhiễm trùng có thể bắt gặp ở bất cứ đâu, ngoài cộng đồng cũng như tại tất cả các Khoa - Phòng trong Bệnh viện. Viện Nam được WHO xếp vào nhóm các quốc gia có tỷ lệ kháng kháng sinh cao nhất thế giới, với tốc độ gia tăng kháng thuốc đáng báo động. Khoảng 88% - 97% kháng sinh được bán tại các nhà thuốc cộng đồng mà không cần kê đơn của bác sĩ, dẫn đến việc lạm dụng và tự dùng thuốc tràn lan. Tỉ lệ kháng thuốc của các vi khuẩn Gram âm gây bệnh phổ biến như E. coli và Klebsiella pneumoniae rất cao, E. coli kháng một số kháng sinh lên tới hơn 70% ở một số khu vực. Vi khuẩn gây nhiễm khuẩn bệnh viện như Acinetobacter baumannii có tỉ lệ kháng với hầu hết các kháng sinh ở mức trên 90%. Các kháng sinh thuộc nhóm mạnh, thường là lựa chọn cuối cùng như Carbapenem, cũng đã bị đề kháng với tỉ lệ cao (khoảng 30% - 80%), làm giảm nghiêm trọng khả năng điều trị bệnh nhân nhiễm khuẩn nặng. Tình trạng nấm Candida spp. đề kháng với thuốc kháng nấm đầu tay Fluconazol cũng đã phổ biến. Việc sử dụng thuốc kháng sinh/ kháng nấm không hợp lý (sai liều, sai chỉ định, không đủ thời gian,..) xảy ra phổ biến cả trong bệnh viện và ngoài cộng đồng.
Trong bối cảnh KKS gia tăng, xét nghiệm kháng sinh đồ là một xét nghiệm thiết yếu, đóng vai trò then chốt trong việc kiểm soát nhiễm khuẩn và bảo tồn hiệu quả của kháng sinh:
-
· Lựa chọn kháng sinh tối ưu: Kháng sinh đồ cho phép xác định chính xác loại kháng sinh nào mà vi khuẩn gây bệnh còn nhạy cảm (Susceptible - S). Điều này giúp bác sĩ chọn được thuốc hiệu quả nhất ngay từ đầu, rút ngắn thời gian điều trị, giảm biến chứng và tỷ lệ tử vong.
· Tránh lãng phí và độc tính: Ngăn chặn việc sử dụng những kháng sinh mà vi khuẩn đã kháng thuốc (Resistant - R), tránh kéo dài thời gian bệnh, giảm độc tính không cần thiết cho bệnh nhân, và tiết kiệm chi phí.
- Ngăn chặn và giám sát kháng thuốc:
· Điều trị trúng đích: Khi có kết quả kháng sinh đồ, bác sĩ có thể sử dụng kháng sinh phổ hẹp hơn nhưng hiệu quả (Liệu pháp xuống thang), thay vì phải dùng kháng sinh phổ rộng (thường mạnh hơn) theo kinh nghiệm, từ đó hạn chế áp lực chọn lọc lên vi khuẩn, làm chậm quá trình kháng thuốc.
· Giám sát dịch tễ: Dữ liệu từ hàng loạt xét nghiệm kháng sinh đồ tại các cơ sở y tế được tổng hợp để theo dõi xu hướng kháng thuốc của vi khuẩn theo thời gian và khu vực. Đây là cơ sở khoa học quan trọng để Bộ Y tế và các bệnh viện xây dựng phác đồ điều trị và hướng dẫn sử dụng kháng sinh phù hợp với tình hình thực tế (kháng sinh đồ tích lũy).
II.
Quy trình nuôi cấy, định danh tìm vi khuẩn gây bệnh và thực hiện kháng sinh đồ gồm các bước:
2.1. Thu thập bệnh phẩm
Trong các bước nêu trên, thu thập bệnh phẩm là một trong các bước đặc biệt quan trọng, ảnh hưởng rất lớn đến kết quả xét nghiệm Vi sinh. Việc thu thập bệnh phẩm cần được tuân thủ theo đúng hướng dẫn dựa trên nguyên tắc "Đúng lúc (chọn đúng thời điểm lấy mẫu: trước khi sử dụng kháng sinh hoặc khi nồng độ kháng sinh thấp nhất là điều đặc biệt quan trọng, kháng sinh có thể gây ức chế làm vi khuẩn/ vi nấm không mọc được,... ) - Đúng chỗ (Lấy đúng vị trí nghi ngờ nhiễm trùng và tập trung nhiều vi khuẩn gây bệnh nhất) - Vô trùng (không làm tạp nhiễm thêm vi sinh vật bên ngoài vào mẫu bệnh phẩm, không đưa thêm tác nhân vào cơ thể bệnh nhân), và cần lấy đủ số lượng để đạt được độ nhạy cao nhất có thể. Việc thu thập bệnh phẩm tuân thủ đúng quy trình sẽ giúp giảm thiểu các kết quả âm tính giả, dương tính giả cũng như giúp vi khuẩn mọc sớm nhất có thể.
2.2.
Sau khi thu thập bệnh phẩm, một số vi khuẩn khi ra ngoài môi trường sẽ dễ bị chết như Streptococcus pneumoniae (Phế cầu), Haemophilus influenzae, Neisseria gonorhoeae (Vi khuẩn lậu),...Các vi khuẩn này đặc biệt thường gặp ở bệnh phẩm đường hô hấp, bệnh phẩm máu, dịch não tủy, dịch mắt, dịch tai, dịch màng tim, dịch ổ khớp, dịch sinh dục, ... do đó cần vận chuyển bệnh phẩm xét nghiệm Vi sinh đến phòng xét nghiệm nhanh nhất có thể (trong vòng 1 - 2 giờ tùy loại bệnh phẩm).
2.3.
Bệnh phẩm được đưa đến Phòng Xét nghiệm Vi sinh sẽ được nuôi cấy trên các môi trường dinh dưỡng và ủ ở điều kiện thích hợp cho vi khuẩn phát triển.
Hình 1. Hình ảnh vi khuẩn mọc trên đĩa thạch dinh dưỡng khi nuôi cấy
Vi khuẩn/ vi nấm gây bệnh thông thường sẽ mọc sau khi nuôi cấy 1 - 2 ngày, thậm chí là chỉ sau 6 - 8 giờ đối với vi khuẩn dễ mọc. Để biết căn nguyên gây bệnh tên là gì, Phòng xét nghiệm cần tiến hành các bước định danh bằng phương pháp thông thường hoặc bằng các hệ thống máy tự động. Thời gian để có kết quả định danh kể từ lúc vi khuẩn mọc có thể chỉ mất vài phút (với các thiết bị hiện đại) cho đến 1 - 2 ngày.

Hình 2. Các hệ thống, kỹ thuật định danh vi khuẩn/ vi nấm
2.5. Kháng sinh đồ
Sau khi nuôi cấy, định danh được vi khuẩn gây bệnh, Phòng xét nghiệm sẽ tiến hành thực hiện kĩ thuật kháng sinh đồ kiểm tra tính nhạy cảm của vi khuẩn/ vi nấm đối với thuốc kháng sinh/ kháng nấm. Quy trình kĩ thuật kháng sinh đồ thường được thực hiện theo hướng dẫn của CLSI (Clinical and Laboratory Standards Institute - Viện Tiêu chuẩn Phòng Xét nghiệm và Lâm sàng - Hoa Kỳ). Kỹ thuật kháng sinh đồ có thể được làm bằng nhiều phương pháp thủ công như: khoanh giấy khuếch tán, dùng dải kháng sinh Etest, kháng sinh đồ pha loãng,...hoặc phương pháp tự động bằng hệ thống máy Phoenix, Vitek,...và thường cho kết quả sau 1 ngày kể từ khi có kết quả định danh, một số ít trường hợp vi khuẩn mọc chậm có thể cần chờ lâu hơn.
Hình 3. Kỹ thuật kháng sinh đồ khoanh giấy khuếch tán
Sau khi có kết quả kháng sinh đồ, việc lựa chọn kháng sinh điều trị sẽ cần dựa vào nhiều yếu tố (liên quan đến Vi sinh học):
-
-
-
Một số chủng vi khuẩn ban đầu nhạy cảm có thể trở nên đề kháng trung gian hoặc đề kháng với kháng sinh sau quá trình điều trị. Do vậy, nên thực hiện thử nghiệm lại kháng sinh đồ để xem xét có xuất hiện đề kháng mới hay không. Hiện tượng xuất hiện đề kháng có thể xảy ra trong khoảng thời gian rất ngắn, 3 đến 4 ngày và rất thường gặp ở:
- - Enterobacter, Citrobacter, và Serratia spp. với nhóm cephalosporins thế hệ 3
- - Pseudomonas aeruginosa với tất cả các loại kháng sinh
- - Staphylococcus spp. với fluoroquinolones.
- - Staphylococcus aureus, chủng nhạy cảm với Vancomycin có thể trở nên trung gian trong quá trình điều trị kéo dài.
Tóm lại, trong thời đại vi khuẩn đa kháng, nuôi cấy - kháng sinh đồ không chỉ là xét nghiệm chẩn đoán mà còn là một công cụ quản lý y tế cộng đồng không thể thiếu. Nuôi cấy - kháng sinh đồ nên được tiến hành trước khi điều trị thuốc kháng sinh/ kháng nấm để đạt được độ nhạy cao nhất của xét nghiệm và tuân thủ quy trình lấy mẫu, bảo quản - vận chuyển mẫu, các quy trình kỹ thuật xét nghiệm,...để đảm bảo chất lượng của xét nghiệm.
Hiện nay, Bệnh viện Ung bướu tỉnh Thanh Hóa đã triển khai thường quy các xét nghiệm nuôi cấy và kháng sinh đồ. Người bệnh khi thực hiện những dịch vụ xét nghiệm này được quỹ bảo hiểm y tế chi trả theo quy định đối với các kỹ thuật nuôi cấy - kháng sinh đồ thông thường.
TÀI LIỆU THAM KHẢO:
1.
2. Clinical and Laboratory Standard Institute (CLSI) (2015). Methods for Dilution Antimicrobial Susceptibility Tests for Bacteria that grow aerobically, M07, 10th ed.
3. Amy L. Leber (2016). Clinical Microbiology Procedures Handbook, 4th ed.
4.
5.
ThS. BSNT. Lê Thị Duyên - Khoa Huyết học - Sinh hóa - Vi sinh
- Mở ra cơ hội tái tạo tuyến vú sau ung thư: Bệnh viện Ung Bướu Thanh Hóa nâng cao chất lượng điều trị toàn diện
- Bứt phá công nghệ – Nâng tầm chẩn đoán
- “Chủ động phòng ngừa – Đẩy lùi ung thư cổ tử cung”
- Vai trò của xét nghiệm AFP trong theo dõi và điều trị ung thư gan
- “Chủ động phòng ngừa – Đẩy lùi ung thư cổ tử cung”
- Thời gian sống trong ung thư: Hiểu đúng để vững tâm điều trị và nâng cao chất lượng sống
- Ung thư đại trực tràng : dấu hiệu nhận biết, các yếu tố nguy cơ, phương pháp chẩn đoán và dự phòng
- Vai trò của xét nghiệm trong chẩn đoán và theo dõi điều trị ung thư tuyến giáp
- SINH THIẾT TỨC THÌ (Frozen section) CÔNG CỤ HỖ TRỢ QUYẾT ĐỊNH PHẪU THUẬT NGAY TRÊN BÀN MỔ
- Ung thư dạ dày – phát hiện sớm để điều trị triệt căn
Tin tức mới nhất
Các ngày trong tuần từ Thứ 2 đến Chủ nhật
Mùa đông: 7:15 - 11:30 | 13:15 - 17:00
Mùa hè: 7:00 - 11:30 | 13:30 - 17:00
Trực cấp cứu: 24/24












